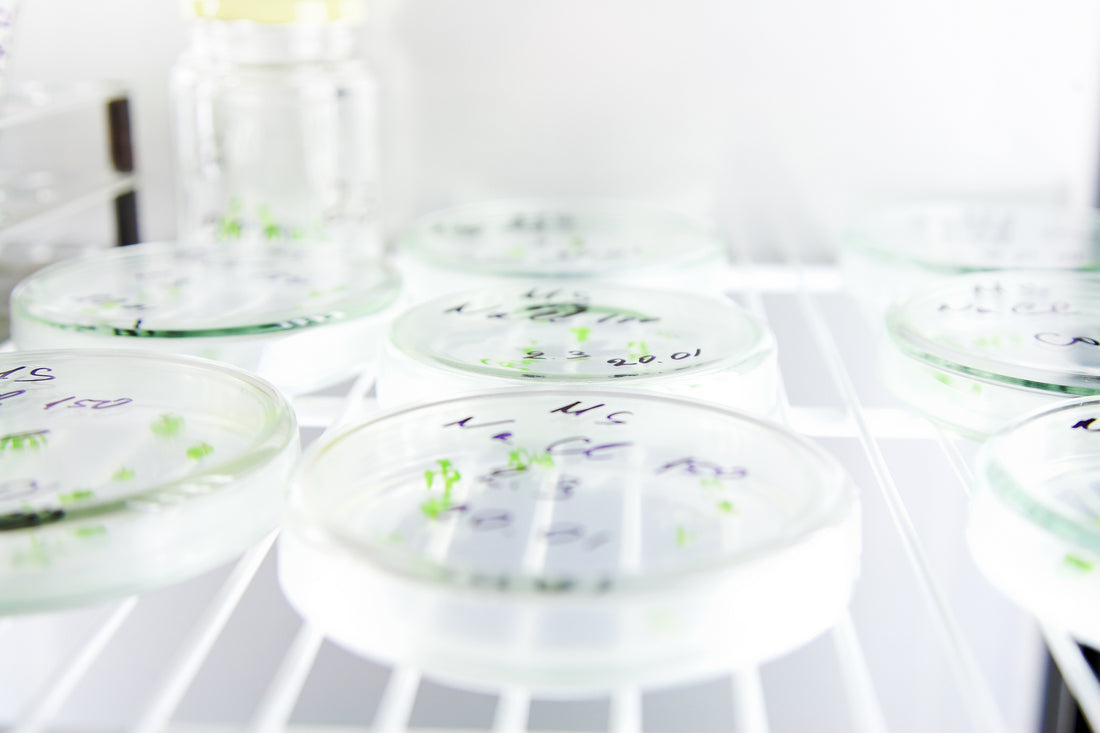

What is Suspension Culture?
As a content and community manager, I leverage my expertise in plant biotechnology, passion for tissue culture, and writing skills to create compelling articles, simplifying intricate scientific concepts, and address your inquiries. As a dedicated science communicator, I strive to spark curiosity and foster a love for science in my audience.


Definition: In this type of culture, single cells or cell aggregates multiply or divide when agitated in a liquid medium.
The suspension cultures of single cells help in the understanding of the growth and developmental processes of a plant.
In the article, “Methods to isolate single cells”, all the methods of single-cell isolation have been discussed. Here, you will learn about different types of suspension culture for isolated single cells and how to assess the growth in these cultures.
Types of Suspension Culture
Broadly speaking, there are two types of suspension culture: Batch Culture and Continuous Culture.
1. Batch Culture
Batch culture is a closed system culture. In this system, the cells are grown in a fixed amount of culture medium under suitable environmental conditions. These are used to initiate single-cell cultures.
Some characteristics of Batch cultures are given below:
- Cells are grown in a 200-250 ml flask.
- It is required to transfer a small aliquot of suspension to a fresh medium.
- The biomass of the culture during incubation time due to cell division and enlargement.
- The Batch culture follows an S-shaped graph shown below. It has three phases: lag phase, in which the cells adjust to the environment and prepare to divide; log or exponential phase, in which the cells divide and enlarge rapidly using the growth medium; and stationary phase, in which cells stop dividing after three to four generations of cell division.

| Figure: The S-shaped graph showing phases of cell growth with time duration. |
- Cells reach the stationary phase either because of exhaustion of some growth factors or accumulation of certain toxic metabolites in the culture medium.
- At the stationary stage of the cells, it is required to transfer the cells to a fresh medium to revive the cell growth.
- If cells existed in the stationary phase it would lead to the death of the cells.
- The cell doubling time varied depending on the type of source plant.
- While subculturing, allow the flask to stand for a few minutes to settle the large clumps of tissue. After this, use a fine syringe to take the suspension from the upper part of the culture.
- According to scientists, batch culture is not suitable to study the growth and metabolism of the cell.
Different types of batch culture include:
- Slowly rotating cultures
- Shake cultures
- Spinning cultures
- Stirred cultures
2. Continuous Culture
Continuous cultures can be open or closed system cultures. In these cultures, the fresh medium is continuously added and the detoxification of the media is avoided by continuously removing leftover nutrients and metabolic end products from the medium.
Some characteristics of the continuous culture are explained below:
- These are especially suitable for growing large-scale cultures in the bioreactors.
- In the closed system continuous culture, the addition of fresh medium is balanced by the outflow of old medium. So, in this case, cell biomass continues to increase with the growth of the cell.
- In the open system continuous culture, the balance is maintained by adding the fresh medium while harvesting the same amount of the culture (containing both, cell and the medium).
Types of continuous culture:
- Chemostat: In this culture, the fresh medium is added while the same amount of the culture is harvested. This maintains steady cell growth. However, the special case in this type of culture is, the concentration of one of the nutrients, nitrogen, phosphorus, and glucose, is adjusted to be growth-limiting.
- Turbidostat: In this culture system, the biomass of the cells are constantly maintained at the level below the maximum yield. All the nutrients are present in excess, unlike one limiting factor as in chemostat culture. The addition of the fresh medium is controlled by the change in the turbidity of the culture (due to cell growth).
What are the methods to assess and measure the growth of cells in suspension culture?
1. Cell counting - the steps to count the cells in suspension cultures are:
- Add 1ml of culture to the 2 ml of chromic trioxide.
- Heat it at 70 ℃ for 2-15 minutes.
- Cool the solution and shake it vigorously for 10 minutes.
- Count the cells in a hemocytometer.
- Packed cell volume (PCV): Transfer a uniformly dispersed suspension to a centrifuge tube and spin it for 5 minutes to calculate the PCV.
2. Cell fresh weight - to calculate the fresh weight, follow the given procedure:
- Fit a circular nylon fabric in Hartley funnel to collect the cells.
- Wash the cells with water.
- Weigh the cells.
3. Cell dry weight - to calculate the fresh weight, follow the given procedure:
- Fit a circular nylon fabric in Hartley funnel to collect the cells.
- Dry the cells for 12 hours at 60 ℃.
- Weigh the cells.
What are the methods to measure and assess the viability of the cells in suspension culture?
- Phase-contrast microscopy: This method works on the principle of observation of cytoplasm streaming and the presence of a healthy nucleus in the suspension.
- Tetrazolium salt reduction: This method measures the respiratory efficiency of the cells by reducing 2,3,5-triphenyl tetrazolium chloride (TTC) to the red dye formazan.
- Fluorescein diacetate (FDA) method: This method calculates the percentage viability of the cells. It works on the principle of illumination of the cell to a fluorescent green color. It occurs due to the release of fluorescein inside cells after the breakdown of fluorescein diacetate due to esterase activity.
- Evan's blue staining: In this method, cells are treated with 0.25 % Evan’s blue stain where the dead cells take up the stain and the viable cells remain unstained.
The preparation of the suspension culture and their growth assessment is then followed by the culturing of the cells. The methods to culture single cells are discussed in the article ”Single-cell culture techniques”.
Reference
- Bhojwani S. S. and Razdan M. K. (1983). Plant Tissue Culture: Theory and Practice. Elsevier publications.
- https://www.urbanpro.com/class-xi-xii-tuition-puc/cell-suspension-culture-plant-tissue-culture
- https://www.biologydiscussion.com/plant-tissues/cell-suspension-culture/cell-suspension-culture-definition-principle-protocol-and-importance-plant-tissue.
Blog Categories
View by Level
Popular Blogs

How Tissue Culture Supports Vertical Farming and Urban Agriculture?
Introduction If you've ever seen a large-scale vertical farm, with its towering racks of perfect, vibrant greens, you might wonder...
Read More
How Bioreactors Are Revolutionizing Large-Scale Micropropagation?
Introduction Have you ever wondered what the secret is to producing thousands, or even hundreds of thousands, of identical, healthy...
Read MoreSubscribe to Our Newsletter
1 comment
Pretty! This has been a really wonderful post. Many thanks for providing this information.
React JS Training in Bangalore
React JS Course in Bangalore
MERN Stack Training in Bangalore
MERN Stack Course in Bangalore
JavaScript Training in Bangalore
UI Development training in Bangalore
UI Development Course in Bangalore
Web Development Training in Bangalore
Web Development Course in Bangalore
Angular Training in Bangalore
JavaScript Course in Bangalore
DSA Training in Bangalore
Best Training Institute in Bangalore
Web Designing Training in Bangalore
Infocampus Training Institute in Bangalore








Join the conversation
Your email address will not be published. Required fields are marked